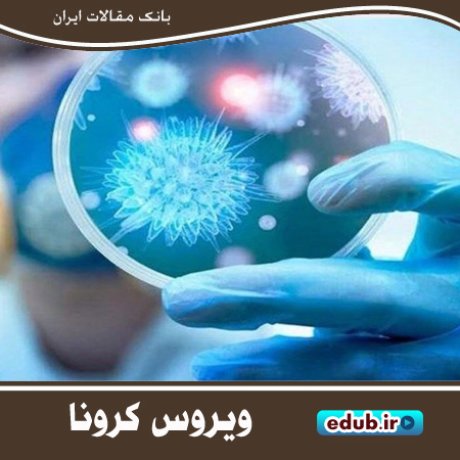

کتاب مرد نخستین (زندگی نامهی داستانی پروفسور سید محمود حسابی)
کتاب کویر - بیکرانه کویر دکتر علی شریعتی
کتاب صیقل روح: پژوهش هایی درباره مولانا
کتاب کویر - معبدی در کویر دکتر علی شریعتی
کتاب رجال سیاسی، هنری و ادبی تاریخ ایران
کتاب کیستی ما، از نگاه روشنفکران ایرانی
کتاب استاد مطهری از نگاه خانواده
کتاب هفده خان عشق: فراز و نشیبهای دلدادگی در نامههای مشاهیر
کتاب گفتوگو با فرهنگمداران ایران و دنیای جدید
کتاب اینشتین میگوید: تو نابغهای
کتاب استیو جابز، زندگینامه موسس اپل
کتاب مردی از جنس ملکوت - نگاهی به زندگی محمود فرشچیان
کتاب سلوک ذیل شخصیت امام خمینی
کتاب معرفی اجمالی آثار استاد مطهری

شکوه بندگی و تجلی ایمان در شبهای قدر
مزیتهای حذف «صفرها» از پول ملی
کرونا و باید و نبایدهای آموزش و پرورش در سال تحصیلی پیشرو
کتاب «قصههای زاگرس» ۵۳ داستان کوتاه از زاگرسنشینان
شبکه شاد ورودی زودهنگام به فضای مجازی
دستورالعمل اجرایی ثبتنام در مدارس ابلاغ شد
فراخوان مقاله برای همایش شمس و مولانا
تامین ۳۵۰ هزار منبع علمی دیجیتال در دانشگاه علامهطباطبایی
کتاب « چالش های جدید حقوق فرزند پذیری»
تصرف هرمز سنگ بنای مناسبات استعماری در خلیج فارس
مقاله رابطه ارزش افزوده اقتصادی و نسبت های سودآوری با ارزش افزوده
مقاله ارزیابی ثبات مالی و تبیین عوامل موثر بر ثبات مالی بانک های کشور
مقاله تاثیر فرایند خصوصی سازی بر شاخص های بهره وری شرکت های واگذار شده
مقاله ساختار بازار داخلی و عملکرد صادراتی بنگاه های صنعتی ایران
مقاله اعتبار نهادهای اقتصادی مبتنی بر مدل های انتزاعی: مطالعه موردی نهاد بازار
مقاله رابطه بین ریسک سیستماتیک و ارزش افزوده اقتصادی در ایران
مقاله بررسی اثر بودجه بر نابرابری منطقهای ایران با استفاده از مدل اقتصاد سنجی فضایی تابلویی
مقاله اثر شوک ارزی بر شاخص ریسک سیستمی صندوقهای سرمایهگذاری مشترک
مقاله واکاوی افول تولید صنعتی پوشاک کشور با رویکرد سیستمی
نسبت اخلاق و سیاست در مواجهه با کرونا
روایت تاریخی جدایی بحرین از ایران

صلح، بهترین راهکار امام حسن(ع) برای ماندگاری اسلام
ایرج زهری؛ منتقد تئاتر و مترجم نمایشنامههای فاخر ادبی
توسعهطلبی روسها؛ از پطرکبیر تا لغو کاپیتولاسیون
اسناد ملی و میراث مکتوب؛ حافظه تاریخی و معرفتی یک ملت
زمزمههای شاعرانهای با نام«لطف یزدان»
معلّم نسلها-نیم قرن پس از «بدیعالزمان فروزانفر» و نکتهای درباب او
روبرتو روسلینی؛ آغازگر و پدرخوانده موج نوی سینمای ایتالیا
موریس مترلینگ؛ شاعر نمادگرا و نویسنده شاهکارهای جاویدان ادبی جهان
بدیعالزمان فروزانفر؛ ادیب و استاد مسلم ادبیات فارسی

ذبیحالله صفا و حماسههای ملّی
کتاب "پا به پای زایندهرود" معرف بزرگترین رود مرکزی ایران
عرفان خان، بازیگری متفاوت در سینمای هند
حضرت خدیجه(س)؛ پشتیبان نبوت و همراهی صادق برای پیامبر(ص)
کتاب "دشت خرّم" مجموعه ای از اشعار میرزا عباسعلی اصفهانی
قرارداد فینکن اشتاین؛ سرآغازی برای معاهدات استعماری دیگر
آزادی مطبوعات؛ سرآغاز تشکیل جامعه مدنی پویا
کتاب «چه کسی از ادوارد آلبی میترسد»
برنامههای درسی دوشنبه ۲۲ اردیبهشت شبکههای آموزش و چهار
مهلت مجدد ثبتنام و ویرایش اطلاعات آزمون کارشناسی ارشد ۹۹
۱۱ خرداد آغاز ثبتنام در آزمون کاردانی نظام جدید
پنجمین فراخوان پذیرش سرباز امریه پژوهشیار
بازگشایی مدارس سراسر کشور از ۲۷ اردیبهشت
تسریع در ترمیم بافتهای آسیبدیده با کمک نانوذرات
شیوهنامه نحوه تأسیس مدارس عالی مهارتی دانشگاه آزاد
فقط دانشجویان دکتری اجازه حضور در دانشگاه را دارند
استفاده از ویروس گیاهی برای درمان بیماریهای خودایمن
ظرفیت پذیرش دانشجو در کارشناسی ناپیوسته ۹۹
زایمان زودرس و سقط جنین از عوارض کمکاری تیروئید در دوران بارداری
شاد؛ شبکهای آموزشی با همه اما و اگرهایش

تغییر زمان برگزاری آزمون دکتری تخصصی وزارت بهداشت